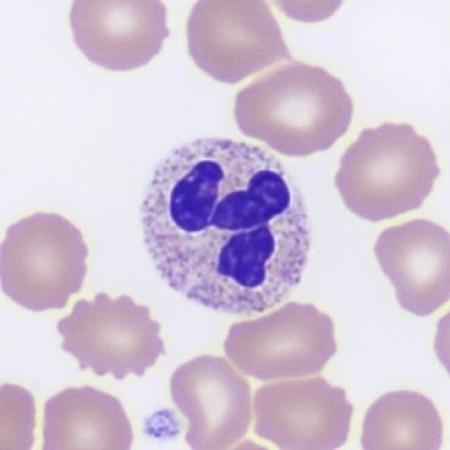
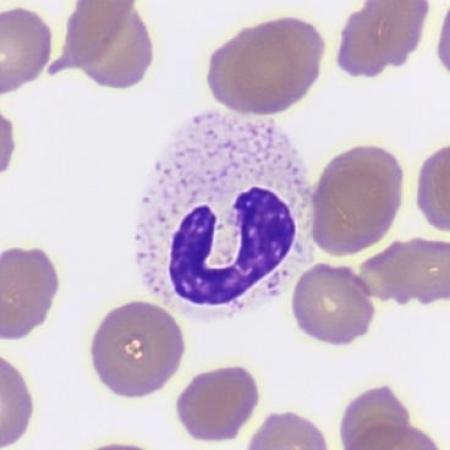
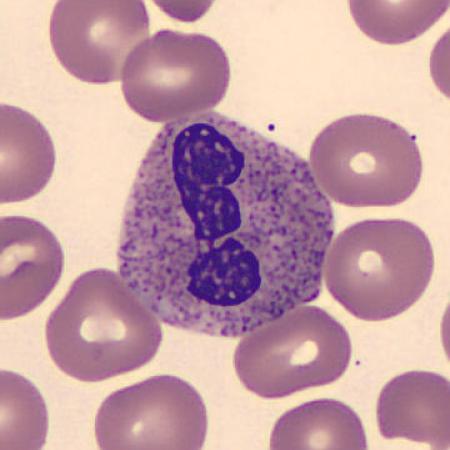

Gimmicks & Games
Welcome to the CellaVision cell image library! If you will come across an interesting-looking cell and would like to contribute to our library, please email us at marketing@cellavision.com.
Letters, Numbers, and Fun Shapes

Neutrophil alphabet



Neutrophil numbers